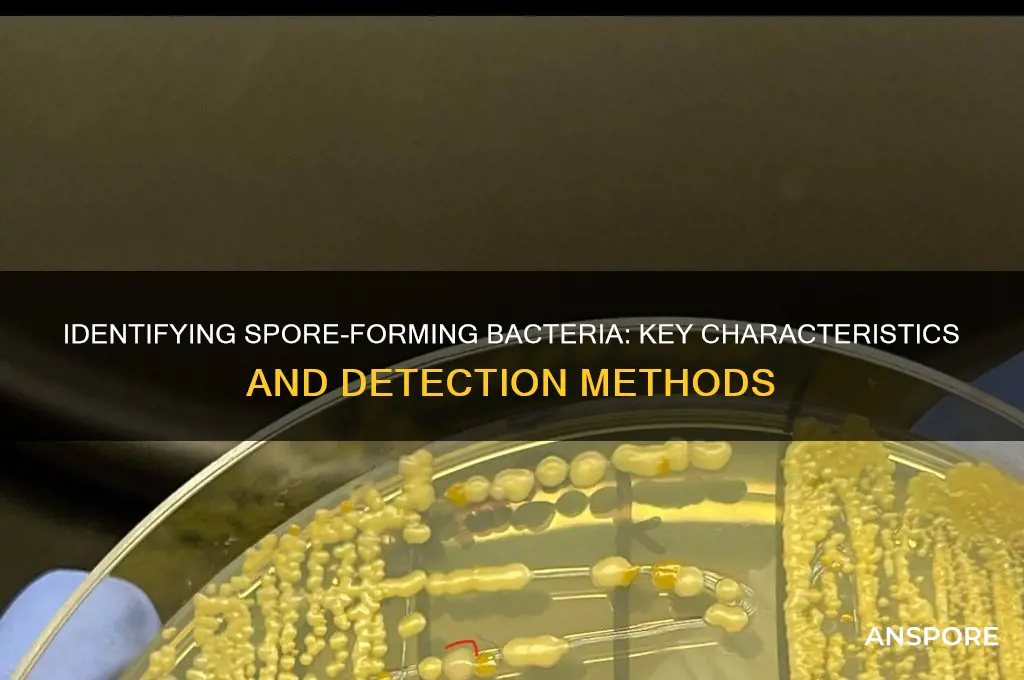
how do you tell if a bacteria forms a spore

Determining whether a bacterium forms spores is crucial for understanding its survival mechanisms and potential risks in various environments. Sporulation is a unique process where certain bacteria, such as *Bacillus* and *Clostridium*, produce highly resistant endospores to withstand harsh conditions like heat, desiccation, and chemicals. To identify spore-forming bacteria, several methods can be employed, including microscopic examination using specialized stains like the Schaeffer-Fulton or Dorner methods, which highlight the spore’s distinct morphology. Additionally, culturing techniques, such as heat treatment to kill vegetative cells while leaving spores intact, followed by incubation to observe growth, are commonly used. Molecular methods, like PCR targeting sporulation-specific genes, provide a more precise and rapid confirmation. Understanding these techniques is essential for fields like microbiology, food safety, and healthcare, where spore-forming bacteria pose significant challenges.
| Characteristics | Values |
|---|---|
| Resistance to Heat | Spores are highly resistant to heat, often surviving temperatures above 100°C (212°F) for extended periods. |
| Resistance to Desiccation | Spores can withstand extreme dryness and remain viable for years in a dormant state. |
| Resistance to Chemicals | Spores are resistant to many disinfectants, including alcohol and some antibiotics. |
| Resistance to Radiation | Spores exhibit high resistance to UV light and ionizing radiation. |
| Morphology | Spores are typically smaller than the vegetative bacterial cell and have a distinct, often oval or spherical shape. |
| Endospore Stain | Spores can be visualized using specific staining techniques like the Schaeffer-Fulton or Dorner endospore stain, appearing as refractile, green, or red bodies within the bacterial cell. |
| Phase Contrast Microscopy | Under phase contrast microscopy, spores appear as bright, refractile bodies within the bacterial cell. |
| Germination Test | Spores can be induced to germinate under specific conditions (e.g., nutrient availability, temperature changes), reverting to vegetative cells. |
| Genetic Markers | Some spore-forming bacteria have specific genes (e.g., spo0A in Bacillus subtilis) involved in sporulation, detectable through molecular techniques. |
| Buoyancy | Spores are often more buoyant than vegetative cells, allowing them to be separated by density gradient centrifugation. |
| Longevity | Spores can remain viable for decades or even centuries in favorable conditions. |
| Species Specificity | Sporulation is a characteristic of specific bacterial genera, such as Bacillus, Clostridium, Sporosarcina, and Desulfotomaculum. |
Explore related products
What You'll Learn
- Spore staining techniques: Methods like Schaeffer-Fulton stain to visualize spores under a microscope
- Heat resistance testing: Spores survive extreme heat, unlike vegetative cells, indicating spore formation
- Phase-contrast microscopy: Observing refractile bodies within bacterial cells, characteristic of endospores
- Germination assays: Testing spore viability by inducing germination under favorable conditions
- Molecular markers: Detecting spore-specific genes or proteins using PCR or immunological methods

Spore staining techniques: Methods like Schaeffer-Fulton stain to visualize spores under a microscope
Bacterial spores are highly resistant structures that enable certain bacteria to survive extreme conditions, but their detection requires specialized techniques. One of the most effective methods to visualize spores under a microscope is the Schaeffer-Fulton stain, a differential staining technique that distinguishes spores from vegetative cells. This method leverages the spore’s impermeability to primary stains, allowing it to retain a distinct color when counterstained. By following precise steps, microbiologists can accurately identify spore-forming bacteria, such as *Bacillus* and *Clostridium* species, in clinical, environmental, or laboratory samples.
The Schaeffer-Fulton stain involves a series of steps that capitalize on the spore’s unique physical properties. First, a heat fixation step is performed to adhere the bacteria to the slide and disrupt the cell wall slightly, enhancing stain penetration. Next, the slide is treated with malachite green, the primary stain, which is heated to facilitate its entry into the vegetative cells but not the spores. After rinsing, the slide is counterstained with safranin, which colors the vegetative cells pink while leaving the spores green. This contrast allows for clear differentiation under a microscope, with spores appearing as bright green ovals within or beside the pink cells.
While the Schaeffer-Fulton stain is widely used, it requires careful attention to detail for optimal results. For instance, overheating the malachite green can lead to non-specific staining, while insufficient heat may fail to drive the stain into the vegetative cells. Additionally, the quality of the heat fixation step is critical; inadequate fixation can cause cells to wash away during rinsing. Practical tips include using a gentle heat source, such as a Bunsen burner or alcohol lamp, and ensuring the slide is evenly heated to avoid uneven staining. For best results, the malachite green should be heated for 3–5 minutes, allowing it to steam without boiling.
Comparatively, other spore staining techniques, like the Wirtz-Conklin method, use different stains (e.g., carbol fuchsin) and may require additional steps, such as decolorization. However, the Schaeffer-Fulton stain remains popular due to its simplicity and reliability. Its ability to produce distinct, easily interpretable results makes it a cornerstone in microbiology education and diagnostic laboratories. For students or researchers new to this technique, practicing on known spore-forming bacteria, such as *Bacillus subtilis*, can help refine skills and ensure accurate identification.
In conclusion, the Schaeffer-Fulton stain is an indispensable tool for detecting bacterial spores, offering a clear visual distinction between spores and vegetative cells. By understanding its principles and mastering its steps, microbiologists can confidently identify spore-forming bacteria, contributing to accurate diagnoses, research, and environmental monitoring. With its combination of precision and accessibility, this technique remains a gold standard in spore visualization.
Create Stunning Fern Spore Prints: A Simple DIY Guide
You may want to see also

Heat resistance testing: Spores survive extreme heat, unlike vegetative cells, indicating spore formation
Spores are nature’s survival capsules, engineered to withstand conditions that would obliterate their vegetative counterparts. One of the most definitive ways to confirm spore formation in bacteria is through heat resistance testing. Exposing bacterial samples to extreme temperatures, typically 80°C (176°F) or higher for 10–30 minutes, serves as a litmus test. Vegetative cells, lacking the protective layers of spores, are rapidly inactivated at such temperatures due to protein denaturation and membrane disruption. In contrast, spores endure, their dormant state and robust outer coats enabling survival. This stark disparity in heat tolerance is a hallmark of spore-forming bacteria like *Bacillus* and *Clostridium*.
To conduct heat resistance testing, prepare a bacterial culture in its exponential growth phase, ensuring a mix of vegetative cells and potential spores. Divide the sample into two aliquots: one untreated (control) and one subjected to heat shock. Incubate both at 80°C for 15 minutes, a standard protocol for spore detection. After cooling, plate both samples onto nutrient agar and observe growth after 24–48 hours. If the heated sample shows viable colonies while the unheated control thrives, spore formation is confirmed. This method is both simple and highly specific, making it a cornerstone in microbiology labs.
The mechanism behind spore survival lies in their structural and biochemical adaptations. Spores possess a thick layer of peptidoglycan, a cortex rich in calcium-dipicolinic acid, and an outer proteinaceous coat. These features act as a thermal shield, stabilizing DNA and proteins against heat-induced damage. For instance, *Bacillus subtilis* spores can survive autoclaving at 121°C (250°F) for 15 minutes, a process routinely used to sterilize lab equipment. Such resilience underscores why spores are a critical concern in food safety, healthcare, and industrial settings, where heat treatment is often insufficient for complete sterilization.
While heat resistance testing is reliable, it’s not without limitations. False negatives can occur if spores are not fully mature or if the heating conditions are inadequate. Conversely, some non-spore-forming bacteria may exhibit partial heat tolerance, complicating interpretation. To mitigate these risks, pair heat testing with microscopy (e.g., phase-contrast or electron microscopy) to visualize spore morphology. Additionally, molecular techniques like PCR targeting spore-specific genes (e.g., *spo0A* in *Bacillus*) can provide genetic confirmation. Combining these approaches ensures accurate identification of spore-forming bacteria.
In practical applications, understanding spore heat resistance is crucial for designing effective sterilization protocols. For example, in the food industry, *Clostridium botulinum* spores require temperatures exceeding 100°C (212°F) for extended periods to ensure safety. Similarly, in healthcare, spore-forming pathogens like *Clostridioides difficile* demand rigorous disinfection methods beyond standard cleaning. By leveraging heat resistance testing, professionals can tailor strategies to target spores specifically, reducing contamination risks and ensuring public safety. This knowledge bridges the gap between laboratory science and real-world problem-solving.
Where to Buy Mold Spores: A Comprehensive Guide for Researchers
You may want to see also

Phase-contrast microscopy: Observing refractile bodies within bacterial cells, characteristic of endospores
Bacterial endospores are highly refractile structures, meaning they bend light significantly due to their dense, electron-rich composition. This optical property makes them stand out under phase-contrast microscopy, a technique that exploits differences in refractive index to create contrast in transparent specimens. When examining bacterial cells suspected of forming endospores, phase-contrast microscopy is a go-to method for visualization without the need for staining, which could alter or damage the sample.
To observe refractile bodies characteristic of endospores, begin by preparing a wet mount of the bacterial culture on a glass slide. Place a small drop of the culture in the center of the slide, then carefully lower a coverslip at a 45-degree angle to avoid air bubbles. Ensure the sample is thin enough to allow light transmission but thick enough to contain intact cells. Once prepared, place the slide on the microscope stage and adjust the phase-contrast condenser and objective to align the annular ring with the light source. This alignment is critical for enhancing contrast and revealing the endospores as bright, oval-shaped bodies within or adjacent to the bacterial cells.
The key to successful observation lies in understanding the optical principles of phase-contrast microscopy. Endospores appear as distinct, refractile bodies due to their high protein and calcium content, which differs markedly from the surrounding cytoplasm. This contrast is further amplified by the phase-contrast setup, which converts minute variations in refractive index into visible differences in light intensity. For optimal results, use a 100x oil-immersion objective to maximize resolution and magnification, allowing for clear differentiation between vegetative cells and endospores.
While phase-contrast microscopy is a powerful tool, it is not without limitations. Overly thick samples or improper alignment of the phase-contrast components can reduce image quality, making endospores difficult to discern. Additionally, not all bacterial species form endospores, so familiarity with the target organism’s morphology is essential. For instance, *Bacillus* and *Clostridium* species are well-known endospore formers, whereas *Escherichia coli* does not produce endospores. Cross-referencing microscopy observations with other diagnostic methods, such as spore staining or molecular techniques, can provide confirmatory evidence.
In practical applications, phase-contrast microscopy is particularly useful in clinical and environmental microbiology for rapid identification of spore-forming bacteria. For example, in a water quality assessment, detecting *Bacillus* endospores can indicate potential contamination from soil or fecal matter. Similarly, in food safety testing, the presence of *Clostridium botulinum* endospores could signal a risk of botulism. By mastering this technique, microbiologists can efficiently screen samples for spore-forming bacteria, enabling timely interventions to prevent disease outbreaks or environmental degradation.
Avoiding Overuse: Balancing Spore Solution Application for Optimal Results
You may want to see also
Explore related products
$12.98 $13.98

Germination assays: Testing spore viability by inducing germination under favorable conditions
Spore-forming bacteria, such as *Bacillus* and *Clostridium* species, produce highly resistant endospores that can survive extreme conditions. Determining whether a bacterium forms spores is crucial for understanding its survival strategies and potential risks. One definitive method to confirm spore formation is through germination assays, which test spore viability by inducing germination under favorable conditions. This technique not only verifies the presence of spores but also assesses their ability to return to active growth, a critical factor in fields like food safety, medicine, and environmental science.
To perform a germination assay, spores are first isolated and purified from a bacterial culture, typically through heat treatment or centrifugation to remove vegetative cells. The purified spores are then exposed to conditions that mimic their natural germination triggers, such as nutrient-rich media, specific temperatures (e.g., 37°C for *Bacillus subtilis*), and pH adjustments. For example, L-alanine at a concentration of 20–100 mM is commonly used as a germinant for *Bacillus* spores, while calcium dipicolinate (Ca-DPA) depletion is another effective method. The assay is monitored over time using techniques like phase-contrast microscopy to observe changes in spore morphology, such as swelling and the emergence of vegetative cells, or by measuring increases in optical density (OD600) to quantify growth.
A key advantage of germination assays is their ability to distinguish between viable and non-viable spores. Non-viable spores fail to germinate under optimal conditions, while viable spores rapidly resume metabolic activity. However, caution must be exercised to avoid false negatives, as some spores may require specific co-germinants or extended incubation times. For instance, *Clostridium* spores often necessitate additional factors like inosine or sodium nitrite for successful germination. Practical tips include using sterile techniques to prevent contamination and including positive and negative controls (e.g., untreated spores and heat-killed spores) to validate the assay’s reliability.
Comparatively, germination assays offer a more functional assessment of spore viability than static methods like staining or heat resistance tests. While the latter confirm spore presence, germination assays provide insights into their physiological state and potential for causing infection or spoilage. This makes them invaluable in industries like food preservation, where understanding spore behavior is essential for developing effective sterilization protocols. For example, a germination assay can reveal whether spores in canned food have survived processing and pose a risk of germination during storage.
In conclusion, germination assays are a powerful tool for testing spore viability by inducing germination under favorable conditions. By combining precision in experimental design with practical considerations, researchers and practitioners can accurately assess spore functionality, ensuring safer products and environments. Whether in a laboratory or industrial setting, mastering this technique is essential for anyone working with spore-forming bacteria.
Does Spore Work on Steam? Compatibility and Performance Explained
You may want to see also

Molecular markers: Detecting spore-specific genes or proteins using PCR or immunological methods
Spore-forming bacteria, such as *Bacillus* and *Clostridium* species, possess unique genetic and proteomic signatures that distinguish them from their non-spore-forming counterparts. Detecting these spore-specific genes or proteins offers a precise and reliable method to identify sporulation capabilities. Molecular markers, including genes like *spo0A* (a master regulator of sporulation) and proteins like small acid-soluble proteins (SASPs), are prime targets for this purpose. By leveraging techniques like polymerase chain reaction (PCR) or immunological assays, researchers can pinpoint these markers with high sensitivity and specificity, even in complex environmental samples.
PCR-based detection of spore-specific genes is a straightforward yet powerful approach. For instance, primers designed to amplify the *spo0A* gene can confirm the presence of sporulation-competent bacteria in a sample. The process involves extracting genomic DNA, amplifying the target gene using specific primers, and visualizing the product via gel electrophoresis. A positive band at the expected size indicates the presence of spore-forming bacteria. This method is particularly useful in food safety and environmental monitoring, where rapid and accurate identification is critical. For optimal results, ensure DNA extraction protocols are optimized to break open spore coats, which can be achieved using mechanical disruption or chemical treatments like lysozyme and proteinase K.
Immunological methods, such as enzyme-linked immunosorbent assay (ELISA) or immunofluorescence, provide an alternative route by targeting spore-specific proteins. SASPs, for example, are highly conserved in spores and can be detected using antibodies raised against these proteins. In an ELISA, spore samples are immobilized, incubated with primary antibodies, and then treated with enzyme-conjugated secondary antibodies. The addition of a substrate produces a measurable color change, quantifying the presence of SASPs. This technique is particularly valuable for high-throughput screening, though it requires careful antibody selection to avoid cross-reactivity with non-spore proteins.
Comparing PCR and immunological methods reveals distinct advantages and limitations. PCR offers unparalleled sensitivity, detecting even low levels of spore-specific genes, but requires careful handling to avoid contamination. Immunological assays, on the other hand, provide rapid results and are less prone to contamination but may lack the sensitivity of PCR, especially in samples with low spore concentrations. The choice of method depends on the specific application: PCR is ideal for confirmatory testing, while immunological assays excel in quick, on-site screening.
In practical terms, combining these molecular approaches can enhance detection robustness. For instance, PCR can be used to confirm the presence of sporulation genes, followed by immunological assays to quantify spore proteins. This dual strategy ensures both accuracy and efficiency, making it a valuable tool in fields like microbiology, biotechnology, and public health. By targeting molecular markers, researchers and practitioners can confidently identify spore-forming bacteria, paving the way for better control and utilization of these resilient organisms.
Is Milky Spore Safe for Dogs? A Pet Owner's Guide
You may want to see also
Frequently asked questions
A bacterial spore is a dormant, highly resistant cell type formed by certain bacteria in response to adverse environmental conditions. Spores can survive extreme temperatures, radiation, and desiccation, allowing the bacteria to persist until more favorable conditions return.
Under a microscope, spores appear as small, refractile (bright) bodies within or next to the bacterial cell. They are often oval or spherical and can be distinguished from the vegetative cell by their size and appearance. Special staining techniques, like the Schaeffer-Fulton stain, can also highlight spores.
The most common test is the heat treatment or spore staining method. Exposing a bacterial culture to high temperatures (e.g., 80°C for 10-15 minutes) kills vegetative cells but leaves spores intact. Subsequent culturing or staining can confirm spore presence.
Common spore-forming bacteria include *Bacillus* (e.g., *B. anthracis*), *Clostridium* (e.g., *C. botulinum*), and *Sporosarcina*. These bacteria are primarily Gram-positive and belong to the phylum Firmicutes.
No, only a limited group of bacteria, primarily in the genera *Bacillus* and *Clostridium*, are capable of forming spores. Most bacteria, including *Escherichia coli* and *Staphylococcus aureus*, do not produce spores.































